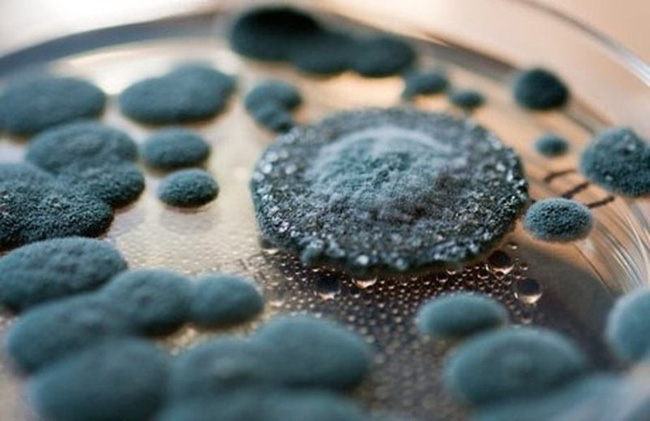

Ung thư là một trong những vấn đề sức khỏe nguy hiểm nhất trên hành tinh. Thống kê của Tổ chức Y tế Thế giới (WHO) cho thấy năm 2008 thế giới có 12,6 triệu người mắc ung thư, trong đó có 7,5 triệu người tử vong.
Khi đối mặt với ung thư, con người chịu thiệt hại rất lớn về sức khỏe và kinh tế để kéo dài thời gian sống và ngăn ngừa khối u di căn. Dù nền y học ngày nay đang trên đà phát triển nhưng chúng ta vẫn chưa có phương pháp điều trị ung thư triệt để, vì vậy giới chuyên gia y tế vẫn khuyến cáo nên "phòng bệnh hơn chữa bệnh".

"Bệnh tật từ miệng mà ra" và ung thư cũng không ngoại lệ...
"Bệnh tật từ miệng mà ra" và ung thư cũng không ngoại lệ, có không ít loại ung thư xuất phát từ nguyên nhân ăn uống. Nếu bạn muốn phòng ngừa căn bệnh này, trước hết hãy xây dựng cho bản thân một chế độ ăn uống lành mạnh, cần tránh xa 4 loại thực phẩm là "chất xúc tác" tạo ra ung thư dưới đây.
1. Thực phẩm chế biến sẵn: Hạn chế ăn để tránh ung thư dạ dày, đại trực tràng
WHO đã đưa ra nhiều bằng chứng thuyết phục cho thấy các loại thịt chế biến sẵn có khả năng gây ung thư, đồng thời xếp thực phẩm này vào danh sách chất gây ung thư Nhóm 1, đặc biệt liên quan đến ung thư đại trực tràng và dạ dày.

Một số loại thịt đã qua chế biến có đặc tính gây ung thư bao gồm: Bánh mì kẹp xúc xích,giăm bông, xúc xích, thịt bò khô...
Một số loại thịt đã qua chế biến có đặc tính gây ung thư bao gồm: Bánh mì kẹp xúc xích, giăm bông, xúc xích, thịt bò khô, thịt đóng hộp... đây đều là những món ăn được trẻ em và cả người lớn vô cùng yêu thích.
Lựa chọn thay thế: Cá trắng, thịt ức gà.
2. Thịt đỏ: Ung thư đại trực tràng
6 món ăn được giới chuyên gia mệnh danh là "sát thủ" phá huỷ gan: Toàn món quen thuộc trong mâm cơm, cần thay đổi nhanh trước khi quá muộn
Dù lành mạnh hơn thịt chế biến sẵn nhưng thịt đỏ vẫn được WHO xếp vào danh sách chất gây ung thư Nhóm 2A nghĩa là "có thể gây ung thư cho con người". Ăn nhiều thịt đỏ có mối liên hệ mạnh nhất với ung thư đại trực tràng, tuy nhiên, cũng có bằng chứng về sự liên quan đến cả ung thư tuyến tụy và tuyến tiền liệt.
Một nghiên cứu được công bố bởi Nhà xuất bản Đại học Oxford, Anh năm 2007 cho biết thịt đỏ chứa một loại protein có khả năng làm tổn thương ruột người, làm tăng nguy cơ ung thư đại trực tràng.
Hội đồng Ung thư Úc khuyến cáo rằng, để giảm nguy cơ ung thư, bạn không nên ăn quá 65-100g thịt đỏ nấu chín mỗi tuần.
Lựa chọn thay thế: Đổi thịt đỏ thành các loại đậu, thịt trắng hoặc cá.

3. Đồ ăn mốc: Ung thư gan
Thức ăn thừa và thực phẩm bị mốc là những món ăn gây ung thư đầu bảng. Các loại ngũ cốc như ngô, bánh mì, gạo... khi bị mốc sẽ chứa nấm mốc, nguy cơ tồn tại độc tố aflatoxin, chất này sẽ gây ung thư cực mạnh cho gan, đã được WHO xếp vào danh sách chất gây ung thư Nhóm 1. Ngoài thực phẩm, aflatoxin còn có thể xuất hiện trên các đồ dùng bị mốc như thớt gỗ, đũa gỗ..
Chỉ 1mg aflatoxin cũng đủ gây ung thư. Nếu ăn một lượng nhỏ trong thời gian dài, aflatoxin có thể liên tục làm tổn thương tế bào gan và cuối cùng gây ung thư gan.
Chỉ 1mg aflatoxin cũng đủ gây ung thư.
4. Đồ uống có đường
Béo phì là một trong những yếu tố nguy cơ chính gây nên bệnh ung thư, vì thế việc duy trì cân nặng vừa phải là vô cùng quan trọng. Nếu bạn tiêu thụ thường xuyên, đồ uống có đường có thể dẫn đến tăng cân, béo phì.
Đồng thời, tiêu thụ quá nhiều đồ uống ngọt chứa đường còn khiến bạn tăng khả năng mắc bệnh tiểu đường, làm rối loạn hoạt động của các tế bào trong ruột, khiến tế bào ung thư dễ xuất hiện hơn.
Theo Trí Thức Trẻ
